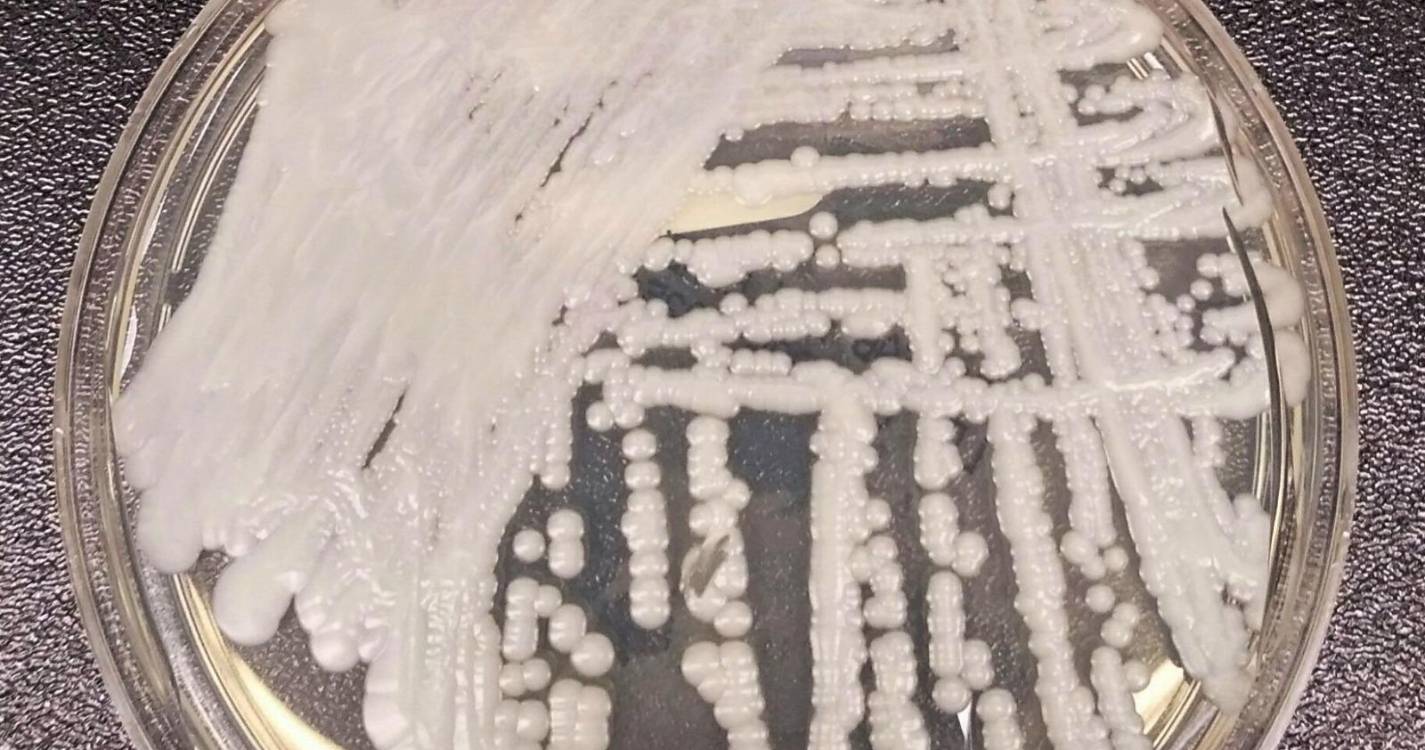
Infeções por Candida auris confirmadas em hospitais públicos entre 2022 e 2025

Infeções por Candida auris confirmadas em hospitais públicos entre 2022 e 2025
O Instituto Nacional de Saúde Ricardo Jorge (INSA) anunciou hoje que foram confirmados casos de infeção pelo fungo Candida auris entre 2022 e 2025 em amostras clínicas de hospitais públicos do Norte e de Lisboa e Vale do Tejo.
O esclarecimento do INSA surge na sequência da divulgação na terça-feira de um estudo liderado pela Faculdade de Medicina da Universidade do Porto, que concluiu ter identificado os primeiros casos em Portugal de Candida auris em 2023.
Foram classificados oito casos identificados em 2023 num hospital da região Norte, refere o resumo do estudo a que a Lusa teve acesso, cujas conclusões reforçam a importância da vigilância hospitalar.
No esclarecimento hoje divulgado, o instituto refere que o primeiro caso de infeção por Candida auris (C. auris) no país foi identificado em 2022 pelo Laboratório Nacional de Referência (LNR) de Infeções Parasitárias e Fúngicas do seu departamento de Doenças Infeciosas.
“Entre 2022 e 2025, o LNR confirmou anualmente casos de infeção por C. auris em amostras clínicas provenientes de diversos hospitais públicos das Regiões de Saúde Norte e Lisboa e Vale do Tejo”, referiu o INSA, sem quantificar o número de infeções.
Embora a Candida auris não faça parte do conjunto de microrganismos de declaração obrigatória no Sistema Nacional de Vigilância Epidemiológica, o LNR do INSA reporta os casos que identifica ao Programa Nacional de Prevenção e Controlo de Infeções e Resistência a Antimicrobianos da Direção-Geral da Saúde (DGS) e, através deste, ao Centro Europeu de Prevenção e Controlo de Doenças (ECDC).
Segundo o INSA, a Candida auris é um “fungo oportunista” humano que se disseminou rapidamente por vários países e continentes e que tem sido associado a um elevado número de surtos.
As infeções “têm aumentado progressivamente nas últimas décadas e tornaram-se uma das principais causas de morbilidade e mortalidade em pacientes em cuidados intensivos”, referiu ainda o instituto.
Isso deve-se principalmente, de acordo com o INSA, ao uso extensivo de antimicrobianos de amplo espetro, à maior taxa de pacientes imunocomprometidos internados em cuidados intensivos e ao tempo de permanência nessas unidades.
A C. auris foi identificada pela primeira vez em 2009 no Japão e, segundo o Centro Europeu de Prevenção e Controlo das Doenças (ECDC na sigla em inglês), foram reportados na União Europeia, entre 2013 e 2021, 1.812 casos de infeções ou portadores do fungo em 15 países, com o último surto registado em 2019-2021 no norte de Itália, com pelo menos 277 casos, alguns deles em pacientes com infeções graves por Covid-19.
A taxa bruta de mortalidade hospitalar por C. auris é estimada entre 30% e 72%, mesmo em pacientes que recebem tratamento antifúngico.